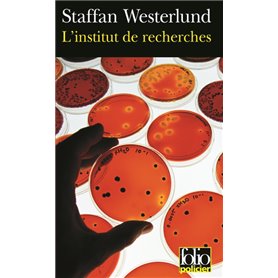

Le Llano en flammes (choix)/El llano en llamas (selección)
10,93 €
≈ 1303 XPF
TTC
Editions FOLIOFormat PocheAuteur : Juan Rulfo